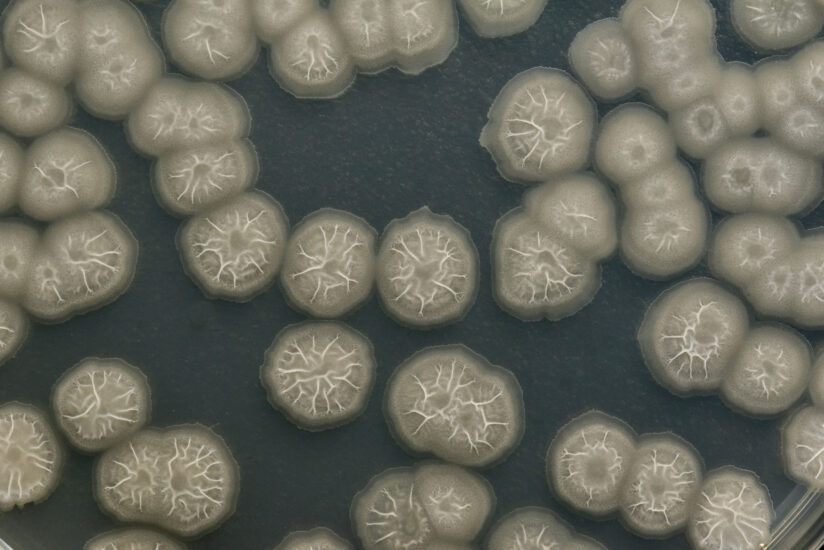

- Home
- Sparks
-
Equities
Equities
View All EquitiesEquities by Sector
- Sectors
-
Thematics
Thematics
View All ThematicsLatest

insight
Investment Companies
VinaCapital Vietnam Opportunity Fund – Vietnam’s path to an investment-grade rating
-
Audiovisual
- Events
-
About Edison
About Edison
-
“Edison is the go-to for a new investor to get full understanding of the investment case and business. Edison’s distribution reaches investors that we want to connect with directly.”
Edison Client
-
- Equity Research
- Investor Relations
- Contact us